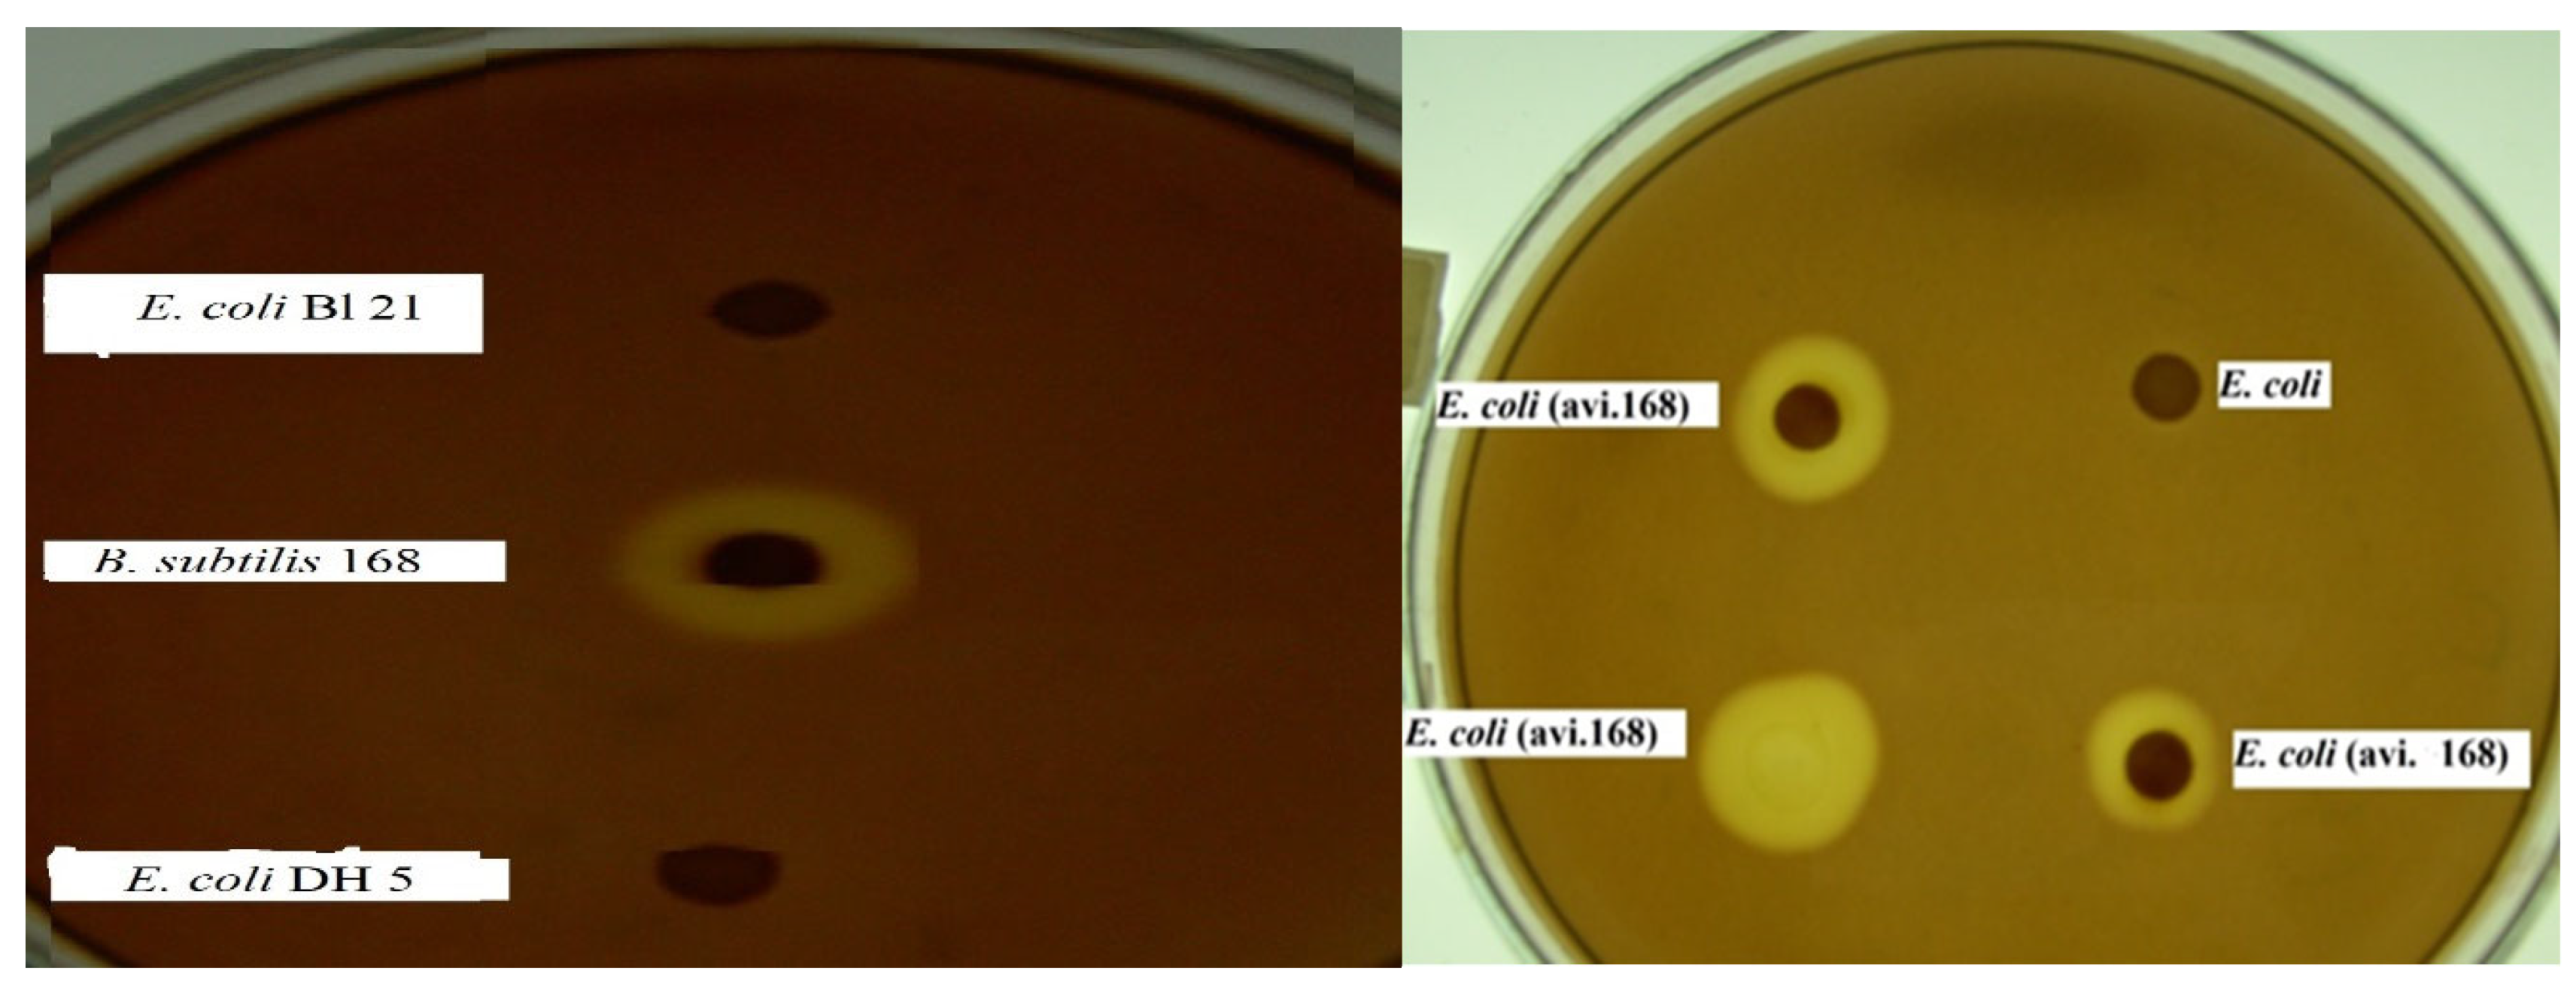
Cleantechnol 05 00023 g005 Cleantechnol 05 00023 g005

Bio Ethanol Production from Rice Straw Saccharification via Avicelase Gene in E. coli Recombinant Strain
Abstract
1. Introduction
2. Materials and Methods
2.1. Microorganisms and Plasmids
2.2. Media
2.3. Bacterium Inoculum
2.4. Screening for Avicelase Production
2.5. Avicelase Assay
2.6. Cloning of Avicelase Gene
2.7. Optimization of Avicelase Expression
2.7.1. Effect of Rich and Minimal Media, and Shaking on Avicelase Activity
2.7.2. Effect of Inorganic Nitrogen and pH on Avicelase Activity
2.8. Utilization of Avicel or Rice Straw by E. coli Transformant
2.9. Pretreatment of Rice Straw
2.10. Rice Straw Saccharification
2.11. Bioethanol Fermentation
Fermentation Efficiently
3. Results and Discussion
3.1. Select Efficient Avicelase Bacterial Strains
3.2. Avicelase Gene Cloning
3.3. Avicelase Expression:
3.4. Avicelase Activity
3.5. Optimized Condition for Avicelase Expression
3.5.1. Effect of Rich and Minimal Media, and Shaking on Avicelase Activity
3.5.2. Effect of Inorganic Nitrogen and pH on Avicelase Activity
3.5.3. Effect of Organic Nitrogen and pH on Avicelase Activity
3.6. Bioethanol Fermentation
4. Conclusions
Author Contributions
Funding
Institutional Review Board Statement
Informed Consent Statement
Data Availability Statement
Acknowledgments
Conflicts of Interest
References
- John, A.J.; Samuel, M.S.; Govarthanan, M.; Selvarajan, E. A comprehensive review on strategic study of cellulase producing marine actinobacteria for biofuel applications. Environ. Res. 2022, 214, 114018. Available online: https://www.sciencedirect.com/science/article/pii/S0013935122013457?via%3Dihub (accessed on 9 August 2022). [CrossRef] [PubMed]
- Patel, S.; Das, D.; Kim, S.; Cho, B.; Kalia, V.; Lee, L. Integrating strategies for sustainable conversion of waste biomass into dark-fermentative hydrogen and value-added products. Renew. Sustain. Energy Rev. 2021, 150, 111491. [Google Scholar] [CrossRef]
- Salleh, S.; Gunawan, M.; Bin Zulkarnain, M.; Shamsuddin, A.; Abdullah, T. Modelling and optimization of biomass supply chain for bioenergy production. J. Environ. Treat. Tech. 2019, 7, 689–695. Available online: https://www.researchgate.net/profile/Muhammad-Fikri-Zulkornain/publication/345471219_Modelling_and_Optimization_of_Biomass_Supply_Chain_for_Bioenergy_Production/links/5fa75e1e92851cc286a01ff8/Modelling-and-Optimization-of-Biomass-Supply-Chain-for-Bioenergy-Production.pdf (accessed on 3 September 2019).
- Huanga, Y.-B.; Fu, Y. Hydrolysis of cellulose to glucose by solid acid catalysts. Green Chem. 2013, 15, 1095–1111. [Google Scholar] [CrossRef]
- Zhang, Q.; Lu, Z.; Su, C.; Feng, Z.; Wang, H.; Yu, J.; Su, W. High yielding, one-step mechano-enzymatic hydrolysis of cellulose to cellulose nanocrystals without bulk solvent. Bioresour. Technol. 2021, 331, 125015, ISSN 0960-8524. [Google Scholar] [CrossRef] [PubMed]
- Terasawat, A.; Phoolphundh, S. Simultaneous Biological Pretreatment and Saccharification of Rice Straw by Ligninolytic Enzymes from Panus neostrigosus I9 and Commercial Cellulase. J. Fungi 2021, 7, 853. [Google Scholar] [CrossRef] [PubMed]
- Takano, M.; Hoshino, K. Bioethanol production from rice straw by simultaneous saccharification and fermentation with statistical optimized cellulase cocktail and fermenting fungus. Bioresour. Bioprocess. 2018, 5, 16. [Google Scholar] [CrossRef]
- Choi, G.W.; Kim, K.H.; Park, C.M.; Lee, K.H.; Lee, D.H. Mixed microbial culture-based consolidated bioprocessing for bioethanol production from oil palm fronds: Effect of inoculum composition and carbon supplementation. Bioresour. Technol. 2021, 335, 125232. [Google Scholar] [CrossRef]
- Zhang, K.; Pei, X.; Zhuang, X. Advances in synthetic biology for enhancing microbial cellulose utilization. Front. Bioeng. Biotechnol. 2020, 8, 1346. [Google Scholar] [CrossRef]
- Zaldivar, J.; Nielsen, J.; Olsson, L. Fuel ethanol production from lignocellulose: A challenge for metabolic engineering and process integration. Appl. Microbiol. Biotechnol. 2001, 56, 17–34. [Google Scholar] [CrossRef]
- AbdElhafez, S.E.; Taha, T.; Mansy, A.E.; El-Desouky, E.; Abu-Saied, M.A.; Eltaher, K.; Hamdy, A.; El Fawal, G.; Gamal, A.; Hashim, A.M.; et al. Experimental Optimization with the Emphasis on Techno-Economic Analysis of Production and Purification of High Value-Added Bioethanol from Sustainable Corn Stover. Energies 2022, 15, 6131. [Google Scholar] [CrossRef]
- Kavitha, S.; Gajendran, T.; Saranya, K.; Selvakumar, P.; Manivasagan, V. Study on consolidated bioprocessing of pre-treated Nannochloropsis gaditana biomass into ethanol under optimal strategy Renew. Energy 2021, 172, 440–452. Available online: https://www.sciencedirect.com/science/article/pii/S0960148121003694 (accessed on 6 March 2021).
- Kavitha, S.; Gajendran, T.; Saranya, K.; Selvakumar, P.; Manivasagan, V.; Jeevitha, S. An insight-A statistical investigation of consolidated bioprocessing of Allium ascalonicum leaves to ethanol using Hangateiclostridium thermocellum KSMK1203 and synthetic consortium Renew. Energy 2022, 187, 403–416. Available online: https://www.sciencedirect.com/science/article/pii/S096014812200057X (accessed on 20 January 2022). [CrossRef]
- Ranjithkumar, M.; Uthandi, S.; Kumar, P.; Muniraj, I.; Thanabal, V.; Rajarathinam, R. Highly crystalline cotton spinning wastes utilization: Pretreatment, optimized hydrolysis and fermentation using Pleurotus florida for bioethanol production. Fuel 2022, 308, 122052. [Google Scholar] [CrossRef]
- Meng, X.; Ragauskas, A.J. Recent advances in understanding the role of cellulose accessibility in enzymatic hydrolysis of lignocellulosic substrates. Curr. Opin. Biotechnol. 2014, 27, 150–158. Available online: https://www.sciencedirect.com/science/article/pii/S0958166914000275 (accessed on 16 February 2023). [CrossRef] [PubMed]
- Singh, A.; Kuhad, R.C.; Ward, O.P. Industrial application of microbial cellulases. In Lignocellul. Biotechnol. Futur. Prospect; I. K. International Pvt Ltd.: Delhi, India, 2007; pp. 345–358. Available online: https://books.google.com/books?hl=en&lr=&id=RIHpe3GBv-YC&oi=fnd&pg=PA345&dq=12.%09A.+Singh,+R.C.+Kuhad,+O.P.+Ward+Industrial+application+of+microbial+cellulases+Lignocellul.+Biotechnol.+Futur.+Prospect.+2007,+pp.+345-358.&ots=eMdiwSvBEj&sig=eO2UGf8fjB-ADZ-K9OTxlGYYTtE (accessed on 1 March 2023).
- Kuhad, R.C.; Mehta, G.; Gupta, R.; Sharma, K.K. Fed batch enzymatic saccharification of newspaper cellulosics improves the sugar content in the hydrolysates and eventually the ethanol fermentation by Saccharomyces cerevisiae. Biomass Bioenergy 2010, 34, 1189–1194. [Google Scholar] [CrossRef]
- Annamalai, N.; Rajeswari, M.V.; Balasubramanian, T. Thermostable and alkaline cellulases from marine sources. In New and Future Developments in Microbial Biotechnology and Bioengineering; Elsevier: Amsterdam, The Netherlands, 2016; pp. 91–98. Available online: https://www.sciencedirect.com/science/article/pii/B9780444635075000095 (accessed on 12 August 2016).
- FIMI. Cellulase Market Outlook; FIMI: Los Angeles, CA, USA, 2022; pp. 2–32. Available online: https://www.futuremarketinsights.com/reports/cellulase-market (accessed on 1 March 2023).
- Whittle, D.J.; Kilburn, D.G.; Warren, R.A.J.; Miller, J.R.C. Molecular Cloning of a Cellulomonas fimi Cellulase Gene in Escherichia coli: Recombinant DNA; Plasmid pBR322; Immunoassay. Gene 1982, 17, 139–145. [Google Scholar] [CrossRef] [PubMed]
- Laymon, R.A.; Adney, W.S.; Mohagheghi, A.; Himmel, M.E.; Thomas, S.R. Cloning and Expression of Full-Length Trichoderma reesei Cellobiohydrolase I cDNA in Escherichia coli. Appl. Biochem. Biotechnol. 1996, 57/58, 389–397. [Google Scholar] [CrossRef]
- Penttila, M.; Andre, L.; Lehtovaara, P.; Bailey, M.; Teeri, T.T.; Knowles, J. Efficient Secretion of Two Cellobiohydrolases by Saccharomyces cerevisiae. Gene 1988, 63, 103–112. [Google Scholar] [CrossRef]
- Zahri, S.; Zamani, M.R.; Motallebi, M.; Sadeghi, M. Cloning and Characterization of CBH II Gene from Trichoderma parceramosum and Its Expression in Pichia pastoris. Iran. J. Biotechnol. 2005, 3, 204–215. Available online: http://www.ijbiotech.com/article_6970.html (accessed on 1 March 2023).
- Hegazy, W.K.; Abdel-Salam, M.S.; Hussain, A.A.; Abo-Ghalia, H.H.; Hafez, S.S. Improvement of cellulose degradation by cloning of endo-β-1, 3-1, 4 glucanase (bgls) gene from Bacillus subtilis BTN7A strain. J. Genet. Eng. Biotechnol. 2018, 16, 281–285. [Google Scholar] [CrossRef] [PubMed]
- Abdel-Salam, M.S.; Hegazy, W.K.; Hussain, A.A.; Abo-Ghalia, H.H.; Hafez, S.S. High ability of cellulose degradation by constructed E. coli recombinant strains. Jordan J. Biol. Sci. 2020, 13, 35–40. Available online: https://jjbs.hu.edu.jo/files/vol13/n1/Binder13n1.pdf (accessed on 1 March 2023).
- Lu, M.; Chang, J.; Wang, P.; Yin, Q.; Dang, X.; Gao, T.; Lu, F. Study on Cellulase Gene Expressed in Pichia pastoris and Analyses of Its Biochemical Characters. J. Mater. Sci. Chem. Eng. 2018, 6, 43–52. [Google Scholar] [CrossRef]
- Zafar, A.; Aftab, M.N.; Asif, A.; Karadag, A.; Peng, L.; Celebioglu, H.U.; Afzal, M.S.; Hamid, A.; Iqbal, I. Efficient biomass saccharification using a novel cellobiohydrolase from Clostridium clariflavum for utilization in biofuel industry. RSC Adv. 2021, 11, 9246–9261. [Google Scholar] [CrossRef]
- Mattam, A.J.; Chaudhari, Y.B.; Velankar, H.R. Factors regulating cellulolytic gene expression in filamentous fungi: An overview. Microb. Cell Fact. 2022, 21, 44. [Google Scholar] [CrossRef]
- Koivula, A.; Ruohonen, L.; Wohlfahrt, G.; Reinikainen, T.; Teeri, T.T.; Piens, K.; Claeyssens, M.; Weber, M.; Vasella, A.; Becker, D.; et al. The Active Site of the Cellobiohydrolase Cel6A from Trichoderma reesei: The Roles of the Aspartic Acids D221 and D175. J. Am. Chem. Soc. 2002, 124, 10015–10024. Available online: https://pubs.acs.org/doi/10.1021/ja012659q (accessed on 2 August 2022). [CrossRef] [PubMed]
- Hussain, A.A.; Abdel-Salam, M.S.; Abo-Ghalia, H.H.; Hegazy, W.K.; Hafez, S.S. Optimization and molecular identification of novel cellulose degrading bacteria isolated from Egyptian environment. J. Genet. Eng. Biotechnol. 2017, 15, 77–85. [Google Scholar] [CrossRef]
- Chen, Z.; Wojcik, S.F.; Welker, N.E. Genetic Analysis of Bacillus stearothermophilus By Protoplast Fusion. J. Bacteriol. 1986, 165, 994–1001. [Google Scholar] [CrossRef]
- Bertani, G. Studies on Lysogenesis. I. The mode of phage liberation by lysogenic Escherichia coli. J. Bacteriol. 1952, 62, 293–300. [Google Scholar] [CrossRef]
- Bushnell, L.D.; Haas, H.F. The utilization of certain hydrocarbons by microorganisms. J. Bacteriol. 1941, 41, 653. [Google Scholar] [CrossRef]
- Kasana, R.C.; Salwan, R.; Dhar, H.; Dutt, S.; Gulati, A. A Rapid and Easy Method for the Detection of Microbial Cellulases on Agar Plates Using Gram’s Iodine. Curr. Microbiol. 2008, 57, 503–507. [Google Scholar] [CrossRef] [PubMed]
- Miller, G.L. Use of dinitrosalicylic acid reagent for determination of reducing sugars. Anal. Chem. 1959, 31, 426–429. Available online: http://pubs.acs.org/doi/abs/10.1021/ac60147a030 (accessed on 1 March 2023). [CrossRef]
- Sambrook, J.; Russell, D.W. (Eds.) Molecular Cloning: A Laboratory Manual; Cold Spring Harbor Laboratory Press: New York, NY, USA, 2001. Available online: https://catalogue.nla.gov.au/Record/2284148 (accessed on 1 March 2023).
- PlasMapper Version 2.0 Software. Available online: http://wishart.biology.ualberta.ca/PlasMapper/ (accessed on 1 March 2023).
- Webcutter 2.0 Software. Available online: http://rna.lundberg.gu.se/cutter2 (accessed on 1 March 2023).
- Rosado, M.J.; Rencoret, J.; Marques, G.; Gutiérrez, A.; del Río, J.C. Structural characteristics of the guaiacyl-rich lignins from rice (Oryza sativa L.) husks and straw. Front. Plant Sci. 2021, 12, 640475. [Google Scholar] [CrossRef]
- Fadel, M.; Hamed, A.A.; Abd-Elaziz, A.M.; Ghanem, M.M.E.; Roshdy, A.M. Cellulases and Animal Feed Production by Solid State Fermentation by Aspergillus fumigatus NRCF-122 mutant. Egypt J. Chem. 2021, 64, 3511–3520. [Google Scholar] [CrossRef]
- Kim, I.; Han, J.I. Optimization of alkaline pretreatment conditions for enhancing glucose yield of rice straw by response surface methodology. Biomass Bioenergy 2012, 46, 210–217. [Google Scholar] [CrossRef]
- Iroba, K.L.; Tabil, L.G.; Dumonceaux, T.; Baik, O.D. Effect of alkaline pretreatment on chemical composition of lignocellulosic biomass using radio frequency heating. Biosyst. Eng. 2013, 116, 385–398. [Google Scholar] [CrossRef]
- Harun, S.; Geok, K. Effect of Sodium Hydroxide Pretreatment on Rice Straw Composition Indian. J. Sci. Technol. 2016, 9, 1–9. Available online: https://sciresol.s3.us-east-2.amazonaws.com/IJST/Articles/2016/Issue-21/Article60.pdf (accessed on 1 March 2023).
- Fadel, M.; Keera, A.A.; Moufi, F.E.; Kahil, T. High level Ethanol from Sugar Cane Molasses by A new Thermo tolerant Saccharomyces cerevisiae Strain in industrial Scale. Biotechnol. Res. Int. 2013, 2013, 253286. [Google Scholar] [CrossRef]
- Fadel, M. Production of Fuel Ethanol from Cane Molasses. In Microbes Process; Nova Science Publisher: Hauppauge, NY, USA, 2014; pp. 93–117. Available online: https://www.researchgate.net/publication/307876553_Production_of_fuel_ethanol_from_cane_molasses (accessed on 1 March 2023).
- Ray, R.R. Microbial Avicelase: An Overview. Bull. Environ. Pharmacol. Life Sci. 2015, 4, 3–13. Available online: https://bepls.com/march_2015/2.pdf (accessed on 1 March 2023).
- Knowles, J.; Lehtovaara, P.; Teeri, T. Cellulase failies and their genes. Trends Biotechnol. 1987, 5, 255–261. [Google Scholar] [CrossRef]
- Toda, H.; Takada, S.; Amano, Y.; Kanda, T.; Okazaki, M.; Shimosaka, M. Expression of a Cellobiohydrolase cDNA from the White Rot Fungus Irpex lacteus in Aspergillus oryzae. J. Appl. Glycosci. 2005, 52, 23–26. [Google Scholar] [CrossRef]
- Toda, H.; Nagahata, N.; Amano, Y.; Nozaki, K.; Kanda, T.; Okazaki, M.; Shimosaka, M. Gene Cloning of Cellobiohydrolase II from the White Rot Fungus Irpex lacteus MC-2 and Its Expression in Pichia pastoris. Biosci. Biotechnol. Biochem. 2008, 72, 3142–3147. [Google Scholar] [CrossRef]
- Jimenez, L.; Vazquez, S.; Turku, A.; Pincus, L. PCR detection, cloning, and genetic identification of microbial cellulases genes in soils. BIOS 2022, 93, 31–48. Available online: https://bioone.org/journals/bios/volume-93/issue-2/BIOS-D-20-00026/PCR-detection-cloning-and-genetic-identification-of-microbial-cellulases-genes/10.1654/BIOS-D-20-00026.short (accessed on 1 March 2023). [CrossRef]
- Ali, S.M.; Soliman, N.A.; Abdal-Aziz, S.A.A.; Abdel-Fattah, Y.R. Cloning of cellulase gene using metagenomic approach of soils collected from Wadi El Natrun, an extremophilic desert valley in Egypt. J. Genet. Eng. Biotechnol. 2022, 20, 20. [Google Scholar] [CrossRef]
- Muammar, A.; Fajrin, S.A.R.; Retnaningrum, E. Cellobiohydrolase A (CBHA) gene cloning from Aspergillus niger to the yeast expression vector as a stages to create cellulosic ethanol strain. AIP Conf. Proc. 2020, 2260, 060003. [Google Scholar] [CrossRef]
- Datsomor, O.; Yan, Q.; Opoku-Mensah, L.; Zhao, G.; Miao, L. Effect of Different Inducer Sources on Cellulase Enzyme Production by White-Rot Basidiomycetes Pleurotus ostreatus and Phanerochaete chrysosporium under Submerged Fermentation. Fermentation 2022, 8, 561. [Google Scholar] [CrossRef]
- Wita, A.; Białas, W.; Wilk, R.; Szychowska, K.; Czaczyk, K. The Influence of Temperature and Nitrogen Source on Cellulolytic Potential of Microbiota Isolated from Natural Environment. Pol. J. Microbiol. 2019, 68, 105–114. [Google Scholar] [CrossRef]
- Kazeem, M.O.; Shah, U.K.M.; Baharuddin, A.S.; Rahman, N.A. Enhanced cellulase production by a novel thermophilic Bacillus licheniformis 2D55: Characterization and application in lignocellulosic saccharification. BioRes. Technol. 2016, 11, 5404–5423. Available online: https://bioresources.cnr.ncsu.edu/BioRes_11/BioRes_11_2_5404_Kazeem_SBR_Enhanced_Cellulsae_Novel_Thermophilic_Agrowaste_8640.pdf (accessed on 1 March 2023). [CrossRef]
- Patel, M.A.; Ou, M.S.; Ingram, L.O.; Shanmugam, K.T. Simultaneous saccharification and co-fermentation of crystalline cellulose and sugarcane bagasse hemicellulose hydrolysate to lactate by a thermotolerant acidophilic Bacillus sp. Biotechnol. Prog. 2005, 21, 1453–1460. [Google Scholar] [CrossRef] [PubMed]
- Karim, A.; Nawaz, M.A.; Aman, A.; Qader, S.A.U. Hyper production of cellulose degrading endo (1,4) β-d-glucanase from Bacillus licheniformis KIBGE-IB2. J. Radia. Res. Appl. Sci. 2015, 8, 160–165. [Google Scholar] [CrossRef]
- Das, A.; Bhattacharya, S.; Murali, L. Production of cellulase from a thermophilic Bacillus sp. isolated from cow dung. Am.-Eurasian J. Agric. Environ. Sci. 2010, 8, 685–691. Available online: https://www.researchgate.net/profile/Dr-Sourav-Bhattacharya/publication/229078196_Production_of_Cellulase_from_a_Thermophilic_Bacillus_sp_Isolated_from_Cow_Dung/links/0ba592c6bd4342ef9d991a96/Production-of-Cellulase-from-a-Thermophilic-Bacillus-sp-Isolated-from-Cow-Dung.pdf (accessed on 1 March 2023).
- Chandra, R.; Takeuchi, H.; Hasegawa, T.; Kumar, R. Improving biodegradability and biogas production of wheat straw substrates using sodium hydroxide and hydrothermal pretreatments. Energy 2012, 43, 273–282. [Google Scholar] [CrossRef]
- Kato, Y.; Nomura, T.; Ogita, S.; Takano, M.; Hoshino, K. Two new β-glucosidases from ethanol-fermenting fungus Mucor circinelloides NBRC 4572: Enzyme purification, functional characterization, and molecular cloning of the gene. Appl. Microbiol. Biotechnol. 2013, 97, 10045–10056. [Google Scholar] [CrossRef] [PubMed]

| Code | Bacterial, Yeast Strains, Plasmids | Reference/Source |
|---|---|---|
| α | E. coli DH5α | Microbial Genetics Dept., NRC |
| 21 | E. coli Bl 21 | Microbial Genetics Dept., NRC |
| BS1 | Bacillus subtilis subsp. subtilis BTN7A | [30] |
| BS2 | Bacillus subtilis subsp. subtilis 168 | Bacillus Genetic Stock Center |
| BS3 | Bacillus subtilis DB100 | Microbial Genetics Dept. NRC |
| BS4 | Bacillus subtilis Ain Shams | Faculty of Science, Ain Shams Univ. |
| BS5 | Bacillus subtilis Al-Azhar | Faculty of Science, Al-Azhar Univ. |
| BM | Bacillus megaterium 7A37 | Bacillus Genetic Stock Center |
| Alk-1 | Bacillus cereus group isolate 1 | Microbial Genetics Dept., NRC, Egypt. |
| Alk-2 | Bacillus cereus group isolate 2 | Microbial Genetics Dept., NRC, Egypt. |
| Anoxy | Anoxybacillus flavithermus BTN7B | [30] |
| Geo. | Geobacillus stearthermophillus 9A5 | [31] |
| Yeast | ||
| Saccharomyces cerevisiae F-307 | Microbial Chemistry Dept., NRC, Egypt. | |
| Plasmid | ||
| pGEM-Teasy | 3015 bp, Ampr | Promega Co. Madison, WI, USA |
| pAvi-168 | pGEM-Teasy with avicelase gene | This study |
| Code | Sequence |
|---|---|
| V-L | TTA AAG AGT ATT GTC GTA AGA CGT GA |
| V-R | GGG GTG GAA GTA ATG AGT GC |
| Bacterial Strain | Specific Activity IU/mg Protein | |
|---|---|---|
| 24 h | 48 h | |
| Bacillus subtilis subsp. subtilis BTN7A | 1.34 | 0.95 |
| Bacillus subtilis subsp. subtilis 168 | 3.29 | 3.88 |
| Bacillus subtilis DB100 | 0.42 | 0.75 |
| Bacillus subtilis Ain Shams | 0.62 | 1.10 |
| Bacillus subtilis Al-Azhar | 0.18 | 1.01 |
| Bacillus megaterium 7A37 | 1.58 | 1.44 |
| Bacillus cereus group isolate 1 | 3.43 | 4.74 |
| Bacillus cereus group isolate 2 | 2.57 | 2.73 |
| Anoxybacillus flavithermus BTN7B | 2.66 | 2.08 |
| Geobacillus stearthermophillus 9A5 | 1.5 | 0.59 |
| Treatment | Avicelase Activity IU/L ± SE * | ||
|---|---|---|---|
| 1st Day | 2nd Day | 3rd Day | |
| LB with shaking | 29 ± 0.59 | 30 ± 0.47 | 39 ± 0.24 |
| LB static | 1 ± 0.18 | 8 ± 0.47 | 12 ± 0.47 |
| BHM with shaking | 3 ± 0.24 | 3 ± 0.24 | 3 ± 0.24 |
| BHM static | 3 ± 0.24 | 1 ± 0.18 | 1 ± 0.09 |
| Parameter | Results ± SE * |
|---|---|
| Ethanol % (v/v) | 5.26 ± 0.47 |
| Residual sugar | 0.09 ± 0.01 |
| Fermentation Efficiency % | 86 ± 0.47 |
Disclaimer/Publisher’s Note: The statements, opinions and data contained in all publications are solely those of the individual author(s) and contributor(s) and not of MDPI and/or the editor(s). MDPI and/or the editor(s) disclaim responsibility for any injury to people or property resulting from any ideas, methods, instructions or products referred to in the content. |
© 2023 by the authors. Licensee MDPI, Basel, Switzerland. This article is an open access article distributed under the terms and conditions of the Creative Commons Attribution (CC BY) license (https://creativecommons.org/licenses/by/4.0/).
Share and Cite
Abdel-Salam, M.S.; Hafez, S.S.; Fadel, M.; Mohamed, S.A.H.; Hegazy, W.K.; Khalil, B.E. Bio Ethanol Production from Rice Straw Saccharification via Avicelase Gene in E. coli Recombinant Strain. Clean Technol. 2023, 5, 451-465. https://doi.org/10.3390/cleantechnol5020023
Abdel-Salam MS, Hafez SS, Fadel M, Mohamed SAH, Hegazy WK, Khalil BE. Bio Ethanol Production from Rice Straw Saccharification via Avicelase Gene in E. coli Recombinant Strain. Clean Technologies. 2023; 5(2):451-465. https://doi.org/10.3390/cleantechnol5020023
Chicago/Turabian StyleAbdel-Salam, Mohamed S., Safa S. Hafez, Mohamed Fadel, Shereen A. H. Mohamed, Wafaa K. Hegazy, and Bigad E. Khalil. 2023. "Bio Ethanol Production from Rice Straw Saccharification via Avicelase Gene in E. coli Recombinant Strain" Clean Technologies 5, no. 2: 451-465. https://doi.org/10.3390/cleantechnol5020023
APA StyleAbdel-Salam, M. S., Hafez, S. S., Fadel, M., Mohamed, S. A. H., Hegazy, W. K., & Khalil, B. E. (2023). Bio Ethanol Production from Rice Straw Saccharification via Avicelase Gene in E. coli Recombinant Strain. Clean Technologies, 5(2), 451-465. https://doi.org/10.3390/cleantechnol5020023
